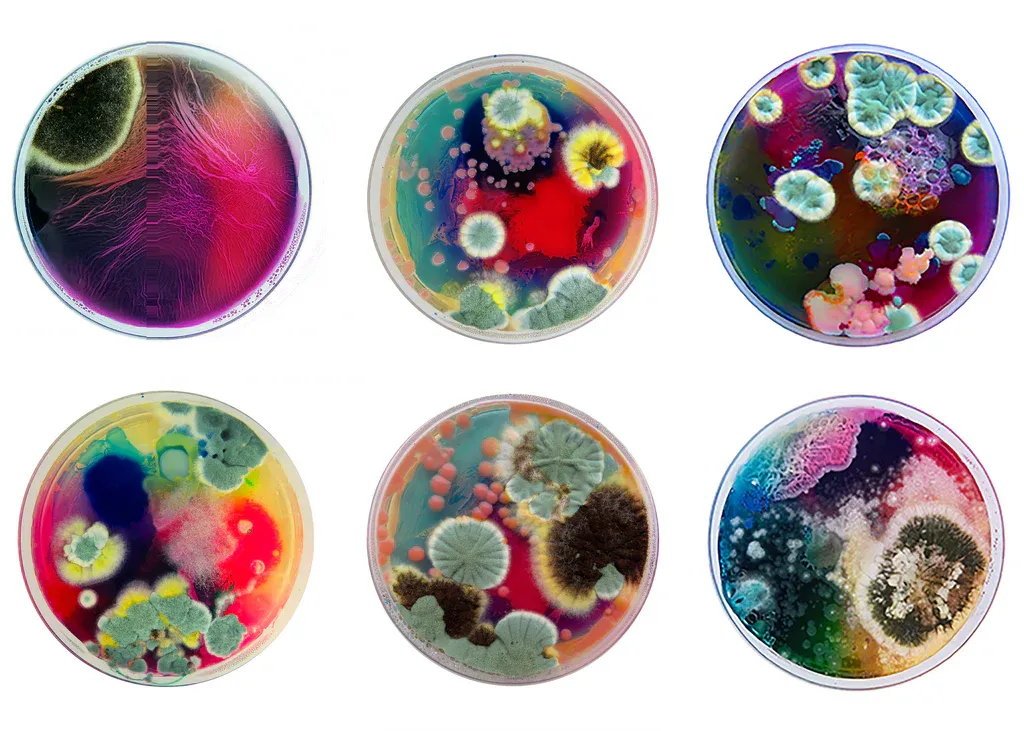
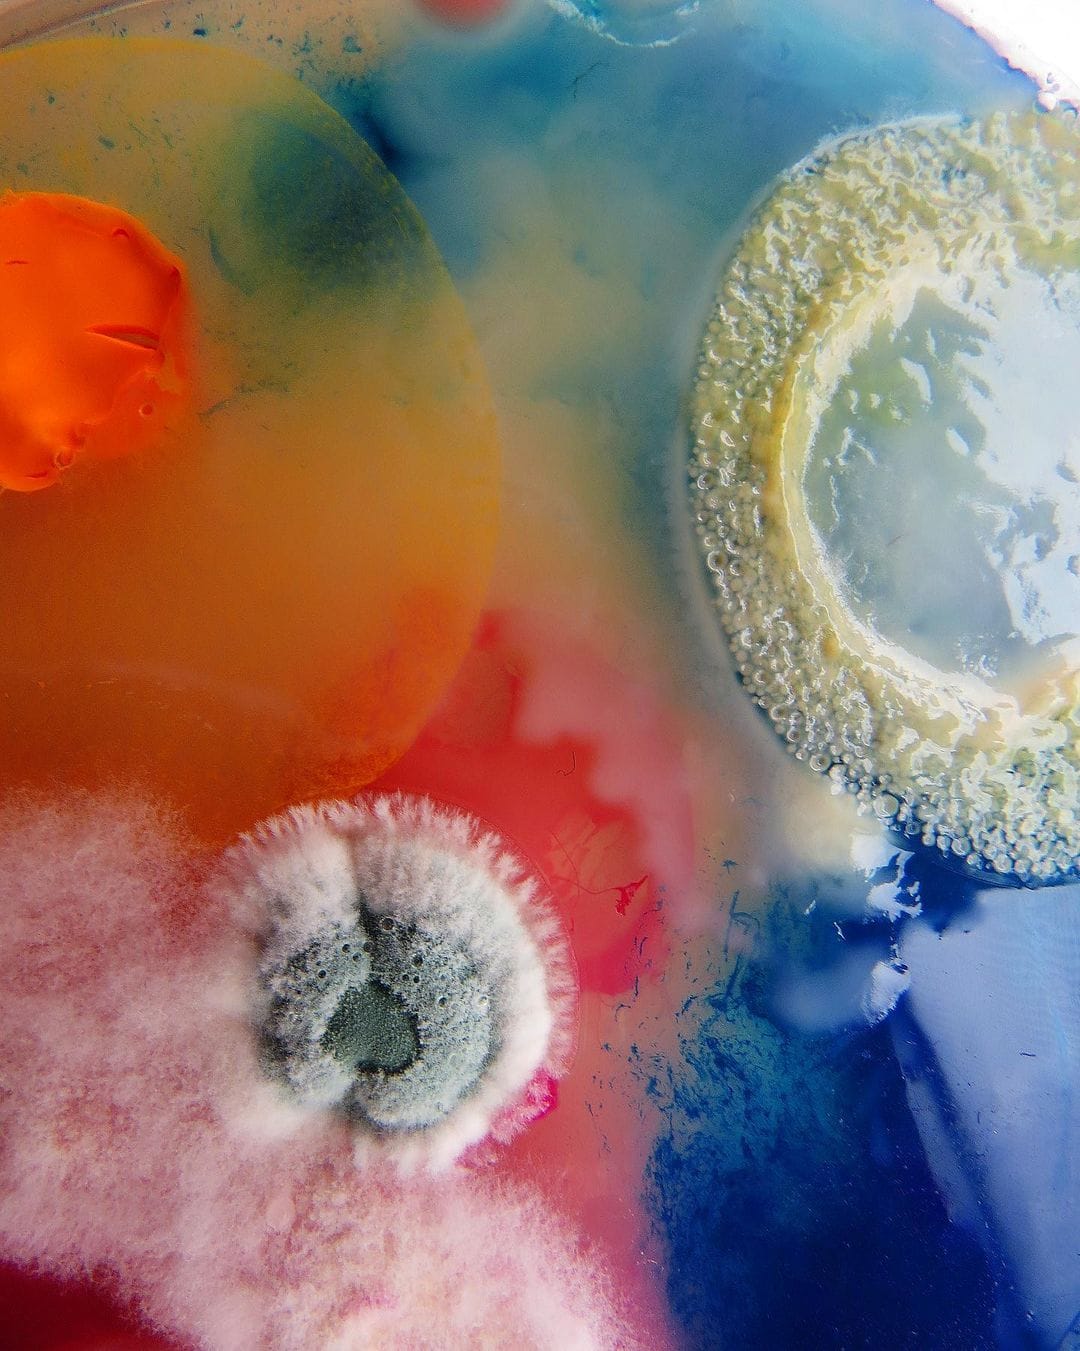
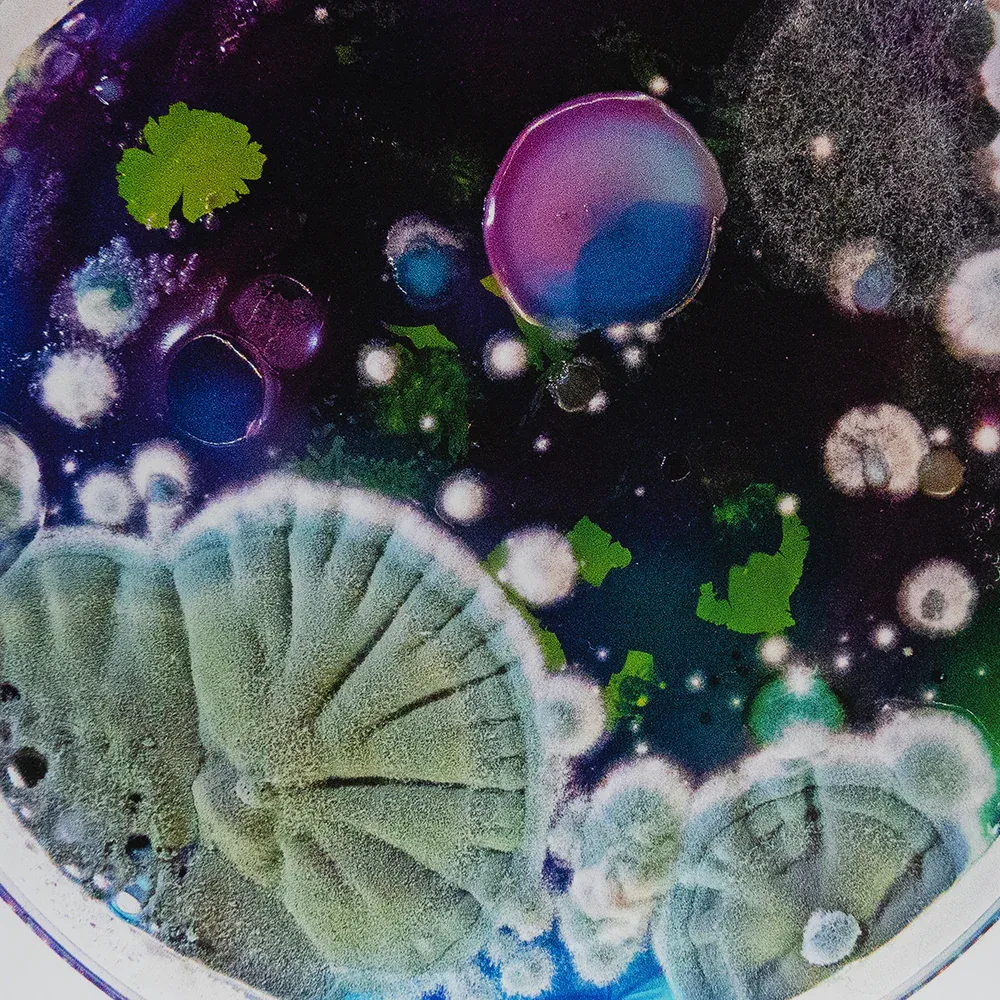

Dasha Plesen
Waarom petrischalen beschilderen als je ook bacteriën het werk kan laten doen. Dat doet Dasha Plesen. Bio art, zoals dat heel on trend heet en ik word er blij van.












Waarom petrischalen beschilderen als je ook bacteriën het werk kan laten doen. Dat doet Dasha Plesen. Bio art, zoals dat heel on trend heet en ik word er blij van.

Vandaag weer even lekker verzopen in de NDL van Japan. En dan vooral omdat ik de term 統計図 heb geleerd. Japans voor statistische grafiek En daar hebben ze er een heleboel van. Veel uit de jaren 1920, dus de een nog mooier dan de anders. Even kijken.
Een voordeel van een abonnement hebben op de kunstgalerij van Samsung is dat je nieuwe dingen ontdekt. Zoals het werk van Isabella Menin. Lente vibes tot en met, dus fijn als je langzaamaan weleens klaar bent met je winterdip. Let’s go!
Heerlijk rustgevende, minimale en tegelijkertijd kleurrijke werken van Valentina Bartolini.
Een goede set infographics uit de Ottomaanse periode: de mid 1920’s. Deze zijn van het ministerie van Justitie vlak na de val van het Ottomaanse rijk. Waar ze precies over gaan, beats me, maar vrij prachtig.